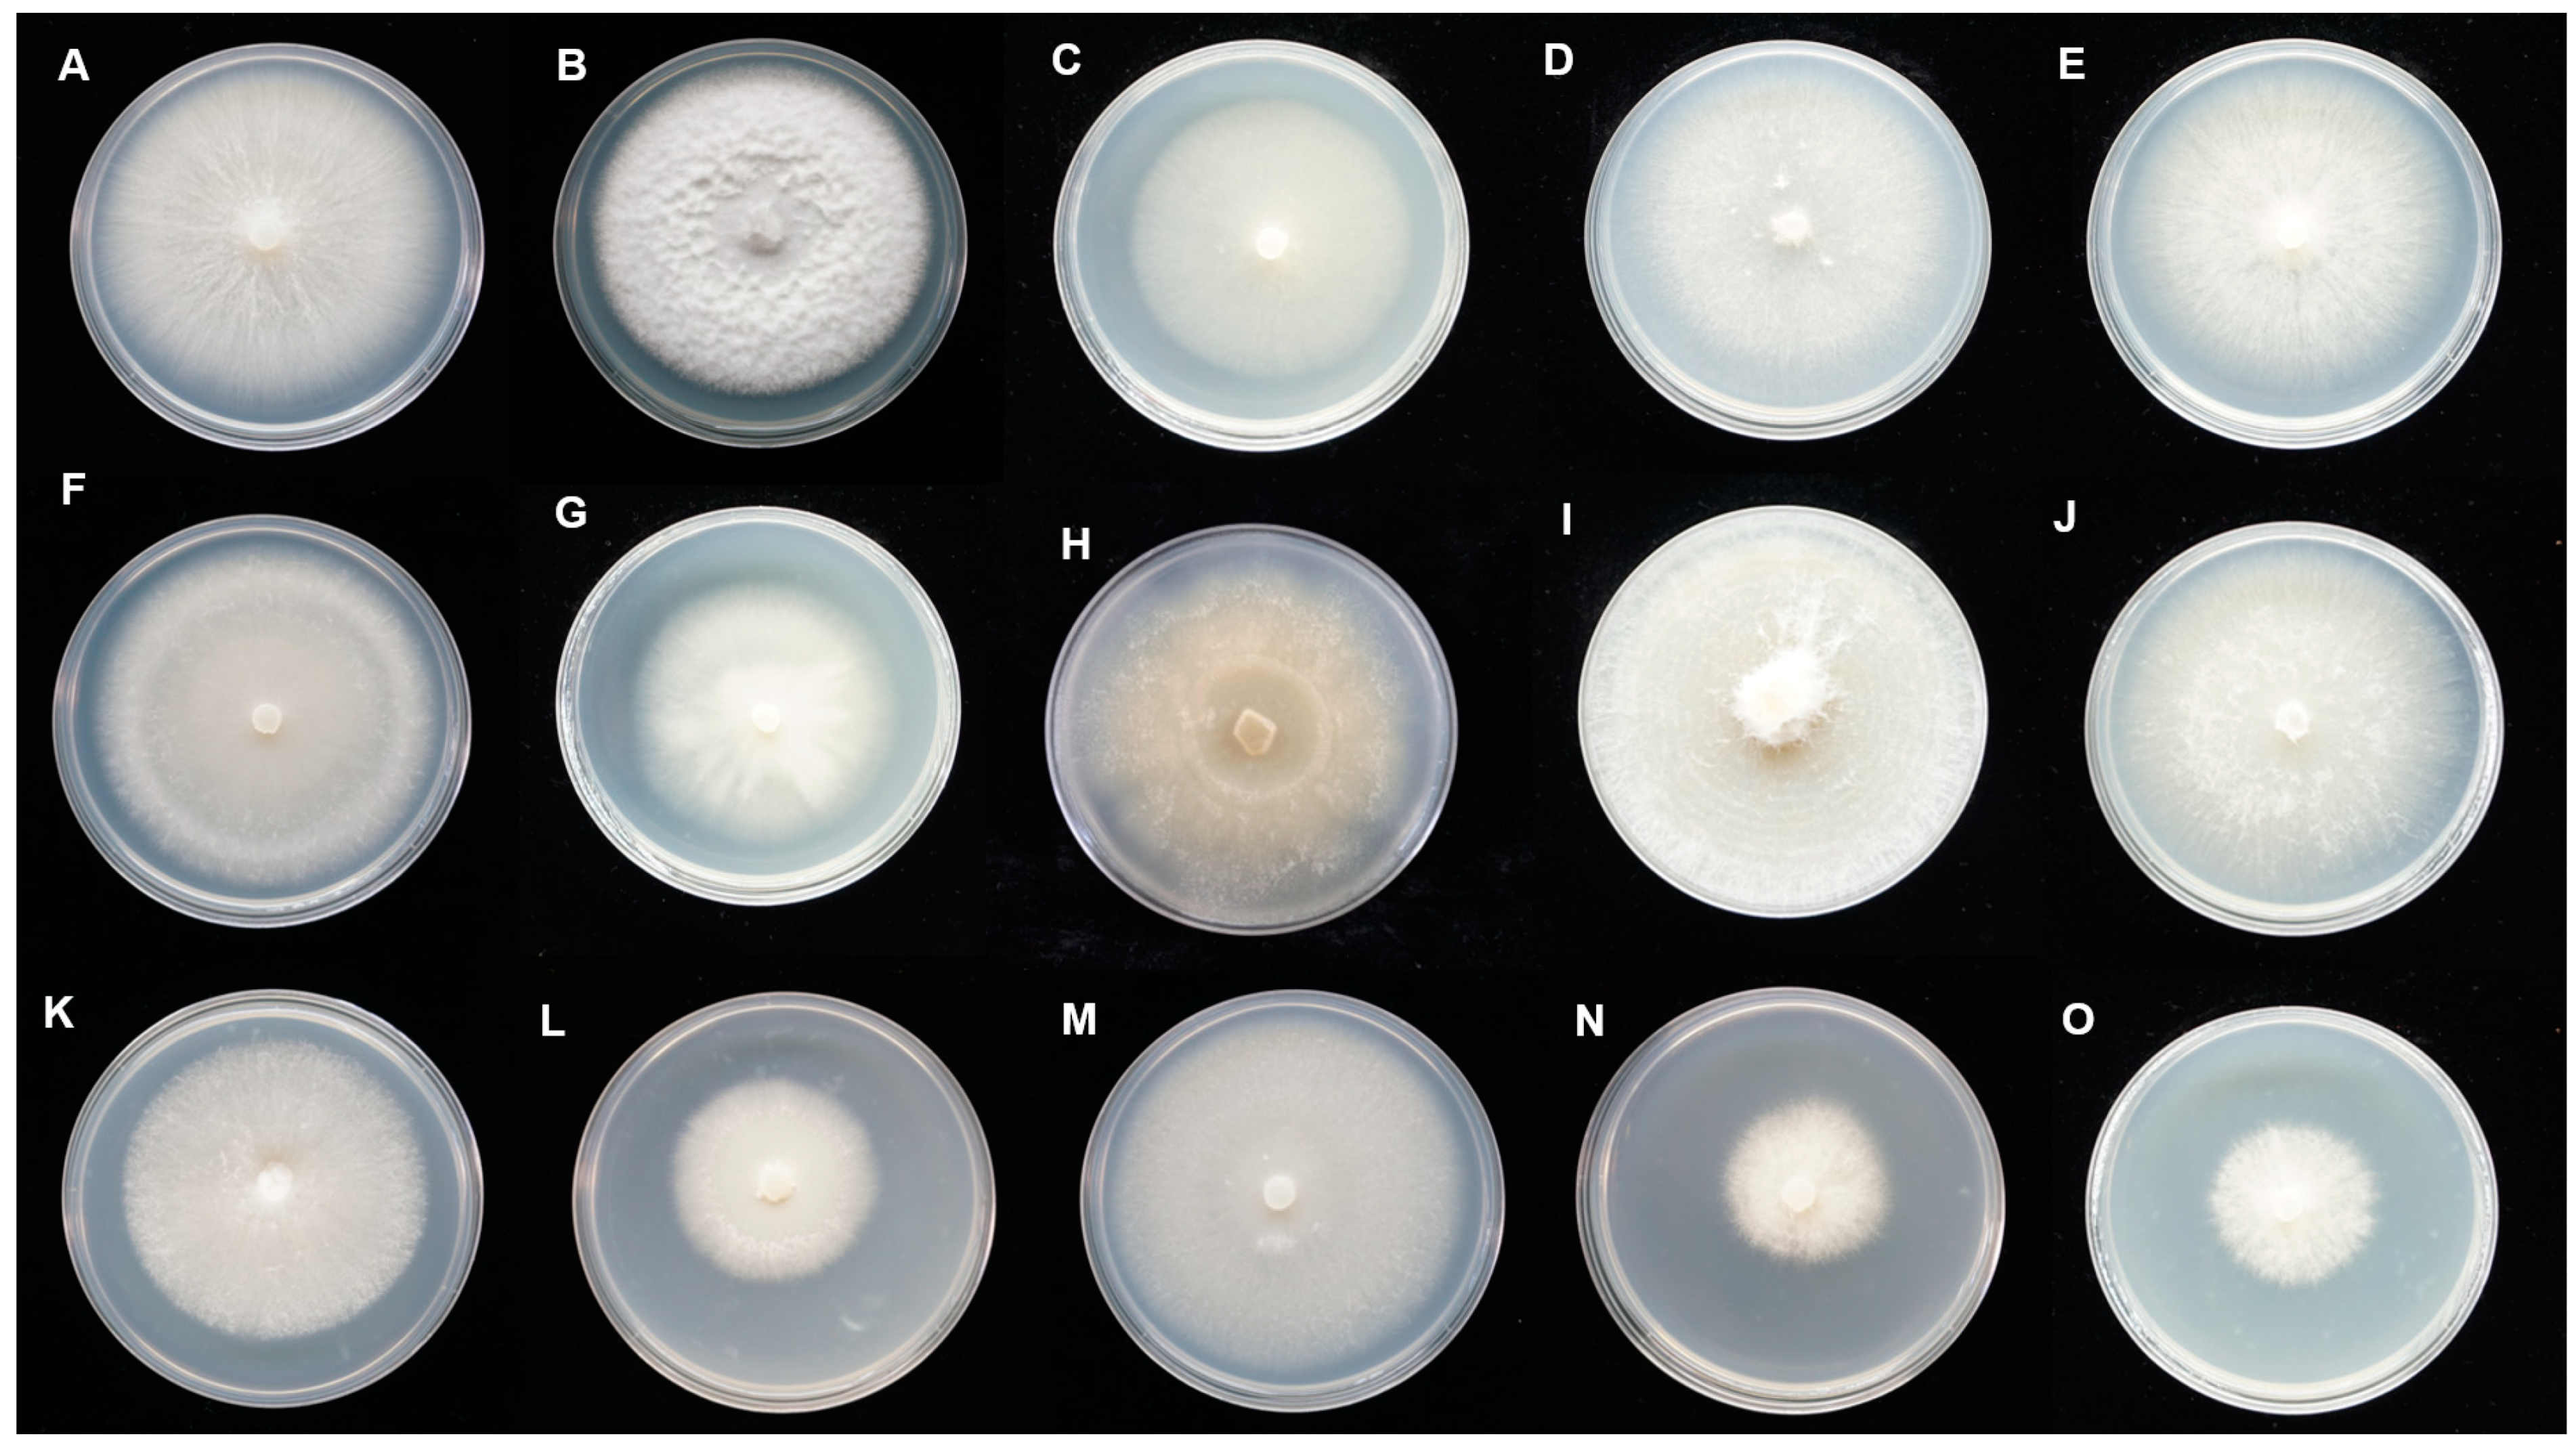
Jof 09 00597 g003a Jof 09 00597 g003a

Isolation of Tulasnella spp. from Cultivated Paphiopedilum Orchids and Screening of Germination-Enhancing Fungi
Abstract
1. Introduction
2. Materials and Methods
2.1. Study Materials

2.2. Fungal Isolation and Identification
2.3. Phylogenetic Analysis of the ITS Sequences
2.4. Screening of Germination-Enhancing Fungi
3. Results
3.1. Fungal Isolation and Morphological Characterization
3.2. Phylogenetic Analysis of the Representative Isolates
3.3. Fungal Capacity to Enhance Germination
4. Discussion
4.1. Fungal Isolates Associated with Paphiopedilum
4.2. Continuous Colonization of Tulasnella in Paphiopedilum
4.3. In Vitro Symbiotic Germination of Paphiopedilum
5. Conclusions
Supplementary Materials
Author Contributions
Funding
Institutional Review Board Statement
Informed Consent Statement
Data Availability Statement
Acknowledgments
Conflicts of Interest
References
- Cribb, P. The Genus Paphiopedilum, 2nd ed.; Natural History Publications: Kota Kinabalu, Malaysia, 1998; pp. 254–260. [Google Scholar]
- Wu, Z.Y.; Raven, P.H.; Hong, D.Y. Flora of China, Volume 25 (Orchidaceae); Science Press: Beijing, China; Missouri Botanical Garden Press: St. Louis, MO, USA, 2009; pp. 33–44. [Google Scholar]
- Liu, Z.J.; Chen, X.Q.; Chen, L.J.; Lei, S.P. The Genus Paphiopedilum in China; Science Press: Beijing, China, 2009; pp. 1–35. [Google Scholar]
- Han, J.Y.; Xiao, H.F.; Gao, J.Y. Seasonal dynamics of mycorrhizal fungi in Paphiopedilum spicerianum (Rchb. f) Pfitzer—A critically endangered orchid from China. Glob. Ecol. Conserv. 2016, 6, 327–338. [Google Scholar] [CrossRef]
- UNEP-WCMC (Comps.). Checklist of CITES Species–CITES Identification Manual; CITES Secretariat: Geneva, Switzerland; UNEPWCMC: Cambridge, UK, 2020; Available online: https://checklist.cites.org/#/en (accessed on 9 March 2023).
- Ye, P.; Wu, J.; An, M.; Chen, H.; Zhao, X.; Jin, X.; Si, Q. Geographical distribution and relationship with environmental factors of Paphiopedilum Subgenus Brachypetalum Hallier (Orchidaceae) taxa in southwest China. Diversity 2021, 13, 634. [Google Scholar] [CrossRef]
- Zhang, Y.Y.; Wu, K.L.; Zhang, J.X.; Deng, R.F.; Duan, J.; da Silva, J.A.T.; Huang, W.C.; Zeng, S.J. Embryo development in association with asymbiotic seed germination in vitro of Paphiopedilum armeniacum S. C. Chen et F. Y. Liu. Sci. Rep. 2015, 5, 16356. [Google Scholar] [CrossRef]
- Fang, L.; Kong, X.P.; Wen, Y.T.; Li, J.; Yin, Y.Y.; Li, L.; Ma, G.H.; Wu, K.L.; Zeng, S.J. Characterization of embryo and protocorm development of Paphiopedilum spicerianum. Plant Physiol. Biochem. 2021, 167, 1024–1034. [Google Scholar] [CrossRef] [PubMed]
- Zeng, S.J.; Huang, W.C.; Wu, K.L.; Zhang, J.X.; da Silva, J.A.T.; Duan, J. In vitro propagation of Paphiopedilum orchids. Crit. Rev. Biotechnol. 2016, 36, 521–534. [Google Scholar] [PubMed]
- Zeng, S.J.; Wu, K.L.; da Silva, J.A.T.; Zhang, J.X.; Chen, Z.L.; Xia, N.H.; Duan, J. Asymbiotic seed germination, seedling development and reintroduction of Paphiopedilum wardii Sumerh., an endangered terrestrial orchid. Sci. Hortic. 2012, 138, 198–209. [Google Scholar] [CrossRef]
- Yang, W.K.; Li, T.Q.; Wu, S.M.; Finnegan, P.M.; Gao, J.Y. Ex situ seed baiting to isolate germination-enhancing fungi for assisted colonization in Paphiopedilum spicerianum, a critically endangered orchid in China. Glob. Ecol. Conserv. 2020, 23, e01147. [Google Scholar] [CrossRef]
- Yuan, L.; Yang, Z.L.; Li, S.Y.; Hu, H.; Huang, J.L. Mycorrhizal specificity, preference, and plasticity of six slipper orchids from South Western China. Mycorrhiza 2010, 20, 559–568. [Google Scholar] [CrossRef]
- Guo, Y.Y.; Luo, Y.B.; Liu, Z.J.; Wang, X.Q. Reticulate evolution and sea-level fluctuations together drove species diversification of slipper orchids (Paphiopedilum) in South-East Asia. Mol. Ecol. 2015, 24, 2838–2855. [Google Scholar] [CrossRef]
- Tian, F.; Liao, X.F.; Wang, L.H.; Bai, X.X.; Yang, Y.B.; Luo, Z.Q.; Yan, F.X. Isolation and identification of beneficial orchid mycorrhizal fungi in Paphiopedilum barbigerum (Orchidaceae). Plant. Signal. Behav. 2022, 31, 2005882. [Google Scholar] [CrossRef]
- Khamchatra, N.; Dixon, K.W.; Tantiwiwat, S.; Piapukiew, J. Symbiotic seed germination of an endangered epiphytic slipper orchid, Paphiopedilum villosum (Lindl.) Stein. from Thailand. S. Afr. J. 2016, 104, 76–81. [Google Scholar] [CrossRef]
- Nontachaiyapoom, S.; Sasirat, S.; Manoch, L. Isolation and identification of rhizoctonia-like fungi from roots of three orchid genera, Paphiopedilum, Dendrobium, and Cymbidium, collected in Chiang Rai and Chiang Mai provinces of Thailand. Mycorrhiza 2010, 20, 459–471. [Google Scholar] [CrossRef]
- Cao, X.; Wang, X.; Wang, T.; Chen, Y.; Yao, N. Dynamic shifts in the root microbiota of cultivated Paphiopedilum armeniacum during different stages of growth. Diversity 2022, 14, 321. [Google Scholar] [CrossRef]
- Linde, C.C.; May, T.W.; Phillips, R.D.; Ruibal, M.; Smith, L.M.; Peakall, R. New species of Tulasnella associated with terrestrial orchids in Australia. IMA Fungus 2017, 8, 27–47. [Google Scholar] [CrossRef] [PubMed]
- Arifin, A.R.; May, T.W.; Linde, C.C. New species of Tulasnella associated with Australian terrestrial orchids in the Cryptostylidinae and Drakaeinae. Mycologia 2020, 113, 212–230. [Google Scholar] [CrossRef] [PubMed]
- Freitas, E.F.S.; Silva, M.D.; Cruz, E.D.S.; Mangaravite, E.; Bocayuva, M.F.; Veloso, T.G.R.; Selosse, M.A.; Kasuya, M.C.M. Diversity of mycorrhizal Tulasnella associated with epiphytic and rupicolous orchids from the Brazilian Atlantic Forest, including four new species. Sci. Rep. 2020, 10, 7069. [Google Scholar] [CrossRef] [PubMed]
- Shefferson, R.P.; Bunch, W.; Cowden, C.C.; Lee, Y.I.; Kartzinel, T.R.; Yukawa, T.; Downing, J.; Jiang, H. Does evolutionary history determine specificity in broad ecological interactions? J. Ecol. 2019, 107, 1582–1593. [Google Scholar] [CrossRef]
- Rayner, R.W. A Mycological Color Chart; Commonwealth Mycological Institute: Kew, UK, 1970. [Google Scholar]
- Wei, J.C. Identification Manual for Fungi; Shanghai Scientific & Technical Publishers: Shanghai, China, 1979. [Google Scholar]
- Pereira, O.L.; Kasuya, M.C.M.; Borges, A.C.; Araújo, E.F. Morphological and molecular characterization of mycorrhizal fungi isolated from neotropical orchids in Brazil. Botany 2005, 83, 54–65. [Google Scholar] [CrossRef]
- Meinhardt, L.W.; Bellato, C.M.; Tsai, S.M. SYBR green I used to evaluate the nuclei number of fungal mycelia. Biotechniques 2001, 31, 42–46. [Google Scholar] [CrossRef]
- White, T.J.; Bruns, T.D.; Lee, S.; Taylor, J.W. Amplification and direct sequencing of fungal ribosomal RNA genes for phylogenetics. In PCR Protocols: A Guide to Methods and Applications; Innis, M.A., Gelfand, D.H., Sninsky, J.J., White, T.J., Eds.; Academic Press: San Diego, CA, USA, 1990; pp. 315–322. [Google Scholar]
- Ji, X.; Wu, D.M.; Song, C.G.; Liu, S.; Si, J.; Cui, B.K. Two new Neofomitella species (Polyporaceae, Basidiomycota) based on morphological and molecular evidence. Mycol. Prog. 2019, 18, 593–602. [Google Scholar] [CrossRef]
- Linde, C.C.; Phillips, R.D.; Crisp, M.D.; Peakall, R. Congruent species delineation of Tulasnella using multiple loci and methods. New Phytol. 2014, 201, 6–12. [Google Scholar] [CrossRef] [PubMed]
- Crous, P.W.; Wingfield, M.J.; Guarro, J.; Hernández-Restrepo, M.; Sutton, D.A.; Acharya, K.; Barber, P.A.; Boekhout, T.; Dimitrov, R.A.; Dueñas, M.; et al. Fungal planet description sheets: 320–370. Persoonia 2015, 34, 250–251. [Google Scholar] [CrossRef] [PubMed]
- Katoh, K.; Standley, D.M. MAFFT multiple sequence alignment software version 7: Improvements in performance and usability. Mol. Biol. Evol. 2013, 30, 772–780. [Google Scholar] [CrossRef] [PubMed]
- Kumar, S.; Stecher, G.; Tamura, K. MEGA 7: Molecular evolutionary genetics analysis version 7.0 for bigger datasets. Mol. Biol. Evol. 2016, 33, 1870–1874. [Google Scholar] [CrossRef] [PubMed]
- Posada, D.; Crandall, K.A. MODELTEST: Testing the model of DNA substitution. Bioinformatics 1998, 14, 817–818. [Google Scholar] [CrossRef]
- Nylander, J.A.A. MrModeltest v2. Program Distributed by the Author; Evolutionary Biology Centre, Uppsala University: Uppsala, Sweden, 2004. [Google Scholar]
- Ronquist, F.; Huelsenbeck, J.P. MrBayes 3: Bayesian phylogenetic inference under mixed models. Bioinformatics 2003, 19, 1572–1574. [Google Scholar] [CrossRef]
- Zi, X.M.; Sheng, C.L.; Goodale, U.M.; Shao, S.C.; Gao, J.Y. In situ seed baiting to isolate germination-enhancing fungi for an epiphytic orchid, Dendrobium aphyllum (Orchidaceae). Mycorrhiza 2014, 24, 487–499. [Google Scholar] [CrossRef]
- Arditti, J. Factors affecting the germination of orchid seeds. Bot. Rev. 1967, 33, 1–97. [Google Scholar] [CrossRef]
- Meng, Y.Y.; Zhang, W.L.; Selosse, M.A.; Gao, J.Y. Are fungi from adult orchid roots the best symbionts at germination? A case study. Mycorrhiza 2019, 29, 541–547. [Google Scholar] [CrossRef]
- Oberwinkler, F.; Cruz, D.; Suárez, J.P. Biogeography and Ecology of Tulasnellaceae. Ecol. Stud. 2017, 230, 237–271. [Google Scholar]
- Shao, S.C.; Luo, Y.; Jacquemyn, H. Successful reintroduction releases pressure on China’s orchid species. Trends Plant Sci. 2022, 27, 211–213. [Google Scholar] [CrossRef] [PubMed]
- McCormick, M.K.; Whigham, D.F.; O’Neill, J. Mycorrhizal diversity in photosynthetic terrestrial orchids. New Phytol. 2004, 163, 425–438. [Google Scholar] [CrossRef]
- Zhang, J. Research on diversity of endosymbiotic fungi in roots of Cymbidium. Master’s Dissertation, Chinese Academy of Forestry, Beijing, China, 2012. [Google Scholar]
- Yamamoto, T.; Miura, C.; Fuji, M.; Nagata, S.; Otani, Y.; Yagame, T.; Yamato, M.; Kaminaka, H. Quantitative evaluation of protocorm growth and fungal colonization in Bletilla striata (Orchidaceae) reveals less-productive symbiosis with a non-native symbiotic fungus. BMC Plant Biol. 2017, 17, 50. [Google Scholar] [CrossRef] [PubMed]
- Ghirardo, A.; Fochi, V.; Lange, B.; Witting, M.; Schnitzler, J.P.; Perotto, S.; Balestrini, R. Metabolomic adjustments in the orchid mycorrhizal fungus Tulasnella calospora during symbiosis with Serapias vomeracea. New Phytol. 2020, 228, 1939–1952. [Google Scholar] [CrossRef] [PubMed]
- Zhou, S.Y.; Zhou, X.; Zhang, Z.F.; Liang, J.M.; Cai, L. Attempt to isolate hitherto uncultured fungi. Mycosystema 2020, 39, 766–776. [Google Scholar]
- Fujimori, S.; Abe, J.P.; Okane, I.; Yamaoka, Y. Three new species in the genus Tulasnella isolated from orchid mycorrhiza of Spiranthes sinensis var. amoena (Orchidaceae). Mycoscience 2019, 60, 71–81. [Google Scholar] [CrossRef]
- Arifin, A.R.; Reiter, N.H.; May, T.W.; Linde, C.C. New species of Tulasnella associated with Australian terrestrial orchids in the subtribes Megastylidinae and Thelymitrinae. Mycologia 2022, 114, 388–412. [Google Scholar] [CrossRef]
- Luo, Y.B.; Jia, J.S.; Wang, C.L. Conservation strategy and potential advantages of the Chinese Paphiopedilum. Biodivers. Sci. 2003, 11, 491–498. [Google Scholar]
- Zhang, F.P.; Huang, J.L.; Zhang, S.B. Trait evolution in the slipper orchid Paphiopedilum (Orchidaceae) in China. Plant Signal. Behav. 2016, 11, e1149668. [Google Scholar] [CrossRef]
- Shefferson, R.P.; Weiß, M.; Kull, T.; Taylor, D.L. High specificity generally characterizes mycorrhizal association in rare lady’s slipper orchids, genus Cypripedium. Mol. Ecol. 2005, 14, 613–626. [Google Scholar] [CrossRef]
- Shefferson, R.P.; Taylor, D.L.; Weiß, M.; Garnica, S.; McCormick, M.K.; Adams, S.; Gray, H.M.; McFarland, J.W.; Kull, T.; Tali, K.; et al. The evolutionary history of mycorrhizal specificity among lady’s slipper orchids. Evolution 2007, 61, 1380–1390. [Google Scholar] [CrossRef] [PubMed]
- Waud, M.; Brys, R.; Landuyt, W.V.; Lievens, B.; Jacquemyn, H. Mycorrhizal specificity does not limit the distribution of an endangered orchid species. Mol. Ecol. 2017, 26, 1687–1701. [Google Scholar] [CrossRef] [PubMed]
- Vannier, N.; Mony, C.; Bittebiere, A.K.; Michon-Coudouel, S.; Biget, M.; Vandenkoornhuyse, P. A microorganisms’ journey between plant generations. Microbiome 2018, 6, 79. [Google Scholar] [CrossRef] [PubMed]
- Perotto, S.; Rodda, M.; Benetti, A.; Sillo, F.; Ercole, E.; Rodda, M.; Girlanda, M.; Murat, C.; Balestrini, R. Gene expression in mycorrhizal orchid protocorms suggests a friendly plant-fungus relationship. Planta 2014, 239, 1337–1349. [Google Scholar] [CrossRef] [PubMed]
- Favre-Godal, Q.; Gourguillon, L.; Lordel-Madeleine, S.; Gindro, K.; Choisy, P. Orchids and their mycorrhizal fungi: An insufficiently explored relationship. Mycorrhiza 2020, 30, 5–22. [Google Scholar] [CrossRef] [PubMed]
- Moreno-Camarena, M.; Ortega-Larrocea, M.P. Mesoamerican Cypripedium: Mycorrhizal Contributions to Promote Their Conservation as Critically Endangered Species. Plants 2022, 11, 1554. [Google Scholar] [CrossRef] [PubMed]
- Voyron, S.; Ercole, E.; Ghignone, S.; Perotto, S.; Girlanda, M. Fine-scale spatial distribution of orchid mycorrhizal fungi in the soil of host-rich grasslands. New Phytol. 2017, 213, 1428–1439. [Google Scholar] [CrossRef]
- Kaur, J.; Phillips, C.; Sharma, J. Host population size is linked to orchid mycorrhizal fungal communities in roots and soil, which are shaped by microenvironment. Mycorrhiza 2021, 31, 17–30. [Google Scholar] [CrossRef]
- Lee, Y.I.; Yeung, E.C.; Lee, N.; Chung, M.C. Embryo development in the lady’s slipper orchid, Paphiopedilum delenatii, with emphasis on the ultrastructure of the suspensor. Ann. Bot. 2006, 98, 1311–1319. [Google Scholar] [CrossRef]
- Fang, L.; Xu, X.; Li, J.; Zheng, F.; Li, M.Z.; Yan, J.W.; Li, Y.; Zhang, X.H.; Li, L.; Ma, G.H.; et al. Transcriptome analysis provides insights into the non-methylated lignin synthesis in Paphiopedilum armeniacum seed. BMC Genom. 2020, 29, 524. [Google Scholar] [CrossRef]
- Rafter, M.; Yokoya, K.; Schofield, E.J.; Zettler, L.W.; Sarasan, V. Non-specific symbiotic germination of Cynorkis purpurea (Thouars) Kraezl., a habitat-specific terrestrial orchid from the Central Highlands of Madagascar. Mycorrhiza 2016, 26, 541–552. [Google Scholar] [CrossRef] [PubMed]
- Huang, H.; Zi, X.M.; Lin, H.; Gao, J.Y. Host-specificity of symbiotic mycorrhizal fungi for enhancing seed germination, protocorm formation and seedling development of over-collected medicinal orchid, Dendrobium devonianum. J. Microbiol. 2018, 56, 42–48. [Google Scholar] [CrossRef] [PubMed]
- Bidartondo, M.I.; Read, D.J. Fungal specificity bottlenecks during orchid germination and development. Mol. Ecol. 2008, 17, 3707–3716. [Google Scholar] [CrossRef] [PubMed]
- Swarts, N.D.; Dixon, K.W. Terrestrial orchid conservation in the age of extinction. Ann. Bot. 2009, 104, 543–556. [Google Scholar] [CrossRef]
- Brundrett, M.C.; Scade, A.; Batty, A.L.; Dixon, K.W.; Sivasithamparam, K. Development of in situ and ex situ seed baiting techniques to detect mycorrhizal fungi from terrestrial orchid habitats. Mycol. Res. 2003, 107, 1210–1220. [Google Scholar] [CrossRef] [PubMed]
- Wu, Y.H.; Chen, D.Y.; Wang, X.J.; Li, N.Q.; Gao, J.Y. Using ex situ seedling baiting to capture seedling associated mycorrhizal fungi in medicinal orchid Dendrobium officinale. J. Fungi 2022, 8, 1036. [Google Scholar] [CrossRef] [PubMed]
- Chen, D.Y.; Wang, X.J.; Li, T.Q.; Li, N.Q.; Gao, J.Y. In situ seedling baiting to isolate plant growth-promoting fungi from Dendrobium officinale, an over-collected medicinal orchid in China. Glob. Ecol. Conserv. 2021, 28, e01659. [Google Scholar] [CrossRef]
- Shao, S.C.; Wang, Q.X.; Beng, K.C.; Zhao, D.K.; Jacquemyn, H. Fungi isolated from host protocorms accelerate symbiotic seed germination in an endangered orchid species (Dendrobium chrysotoxum) from southern China. Mycorrhiza 2020, 30, 529–539. [Google Scholar] [CrossRef]
- Gao, Y.Y.; Peng, S.J.; Hang, Y.; Xie, G.F.; Ji, N.; Zhang, M.S. Mycorrhizal fungus Coprinellus disseminatus influences seed germination of the terrestrial orchid Cremastra appendiculata (D. Don) Makino. Sci. Hortic-Amst. 2022, 293, 110724. [Google Scholar] [CrossRef]
- Herrera, H.; Valadares, R.; Contreras, D.; Bashan, Y.; Arriagada, C. Mycorrhizal compatibility and symbiotic seed germination of orchids from the Coastal Range and Andes in south central Chile. Mycorrhiza 2017, 27, 175–188. [Google Scholar] [CrossRef]

| No. | Fungal Isolate | Orchid | Accession Number | Closest Match in GenBank | Percentage Identity (%) | Source of Closest Matching Fungi | Culturable |
|---|---|---|---|---|---|---|---|
| 1 | parm152 | P. armeniacum | OQ672311 | MN918479 | 100 | NA | Isolate |
| 2 | parm31 | P. armeniacum | OQ678371 | GQ241853 | 99.39 | P. armeniacum | Uncultured |
| 3 | parm382 | P. armeniacum | OQ678373 | GQ241853 | 98.69 | P. armeniacum | Uncultured |
| 4 | parm451 | P. armeniacum | OQ678390 | GQ241817 | 99.51 | P. micranthum | Uncultured |
| 5 | parm712 | P. armeniacum | OQ678395 | KF537647 | 99.01 | Liparis japonica | Isolate |
| 6 | parm95 | P. armeniacum | OQ672331 | JQ247568 | 100 | soil | Isolate |
| 7 | parmf59 | P. armeniacum | OQ678372 | GQ241854 | 100 | P. armeniacum | Uncultured |
| 8 | parmf61 | P. armeniacum | OQ672383 | KX387616 | 99.6 | P. hirsutissimum | Uncultured |
| 9 | pbs1191 | P. villosum | OQ678396 | GU166415 | 99.66 | P. charlesworthii | Isolate |
| 10 | pemer202 | P. emersonii | OQ678398 | OP740400 | 100 | Habenaria longicornu | Isolate |
| 11 | pgrat15 | P. gratrixianum | OQ678358 | EF393621 | 98.99 | Cymbidium floribundum | Isolate |
| 12 | pgrat61 | P. gratrixianum | OQ678359 | FJ940903 | 96.64 | Pecteilis susannae | Isolate |
| 13 | pgrat632 | P. gratrixianum | OQ678357 | GQ241842 | 98.96 | P. dianthum | Uncultured |
| 14 | phir882 | P. hirsutissimum | OQ678360 | GU166423 | 99.45 | Cymbidium | Isolate |
| 15 | Php12 | P. hirsutissimum | MT804628 | OQ148693 | 98.94 | Dendrobium flexicaule | Isolate |
| 16 | Php18 | P. callosum | MW221315 | GU166421 | 99.82 | P. villosum | Isolate |
| 17 | Php25 | P. henryanum | MW221330 | KX387600 | 99.81 | P. dianthum | Uncultured |
| 18 | pjack49 | P. malipoense | OQ678361 | GQ241829 | 98.76 | P. micranthum | Uncultured |
| 19 | pmi16 | P. micranthum | OQ678362 | GQ241818 | 99.82 | P. micranthum | Uncultured |
| 20 | pmilg281 | P. micranthum | OQ678363 | GQ241857 | 98.05 | P. micranthum | Uncultured |
| 21 | pmir45 | P. micranthum | OQ678402 | GQ241818 | 97.47 | P. micranthum | Uncultured |
| 22 | pmir712 | P. micranthum | OQ678364 | OL638255 | 98.15 | Cymbidium goeringii | Isolate |
| 23 | ppur922 | P. purpuratum | OQ678365 | GU166424 | 97 | P. callosum | Isolate |
| 24 | prhi65 | P. rhizomatosum | OQ678366 | KX387600 | 99.64 | P. dianthum | Uncultured |
| 25 | prhi68 | P. rhizomatosum | OQ678367 | GQ241830 | 99.64 | P. micranthum | Uncultured |
| 26 | ptigf131 | P. tigrinum | OQ678368 | KC478574 | 97.34 | Phragmipedium longifolium | Uncultured |
| 27 | pwar205 | P. wardii | OQ678406 | AJ313448 | 99.16 | Oncidium | Isolate |
| 28 | pwar310 | P. wardii | OQ678369 | MW432189 | 99.82 | Dendrobium officinale | Isolate |
| 29 | pwen31 | P. wenshanense | OQ678370 | GQ241830 | 99.53 | P. micranthum | Uncultured |
Disclaimer/Publisher’s Note: The statements, opinions and data contained in all publications are solely those of the individual author(s) and contributor(s) and not of MDPI and/or the editor(s). MDPI and/or the editor(s) disclaim responsibility for any injury to people or property resulting from any ideas, methods, instructions or products referred to in the content. |
© 2023 by the authors. Licensee MDPI, Basel, Switzerland. This article is an open access article distributed under the terms and conditions of the Creative Commons Attribution (CC BY) license (https://creativecommons.org/licenses/by/4.0/).
Share and Cite
Yao, N.; Zheng, B.; Wang, T.; Cao, X. Isolation of Tulasnella spp. from Cultivated Paphiopedilum Orchids and Screening of Germination-Enhancing Fungi. J. Fungi 2023, 9, 597. https://doi.org/10.3390/jof9060597
Yao N, Zheng B, Wang T, Cao X. Isolation of Tulasnella spp. from Cultivated Paphiopedilum Orchids and Screening of Germination-Enhancing Fungi. Journal of Fungi. 2023; 9(6):597. https://doi.org/10.3390/jof9060597
Chicago/Turabian StyleYao, Na, Baoqiang Zheng, Tao Wang, and Xiaolu Cao. 2023. "Isolation of Tulasnella spp. from Cultivated Paphiopedilum Orchids and Screening of Germination-Enhancing Fungi" Journal of Fungi 9, no. 6: 597. https://doi.org/10.3390/jof9060597
APA StyleYao, N., Zheng, B., Wang, T., & Cao, X. (2023). Isolation of Tulasnella spp. from Cultivated Paphiopedilum Orchids and Screening of Germination-Enhancing Fungi. Journal of Fungi, 9(6), 597. https://doi.org/10.3390/jof9060597

